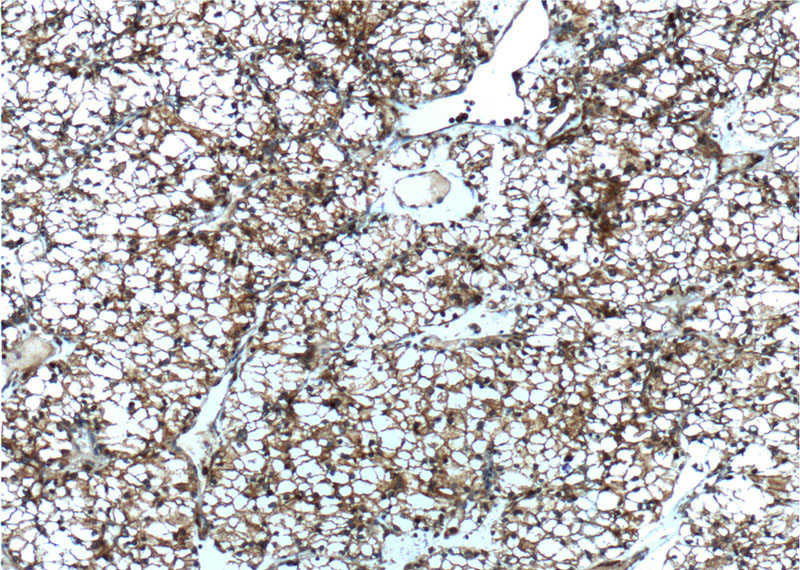
Immunohistochemistry of paraffin-embedded human renal cell carcinoma tissue slide using Catalog No:107524(SEPT2 Antibody) at dilution of 1:800 (under 10x lens). heat mediated antigen retrieved with Tris-EDTA buffer(pH9).

-
Product Name
SEPT2 antibody
- Documents
-
Description
SEPT2 Mouse Monoclonal antibody. Positive WB detected in HEK-293 cells, fetal human brain tissue, HeLa cells, human brain tissue, human testis tissue, Jurkat cells. Positive IF detected in hTERT-RPE cells. Positive IHC detected in human renal cell carcinoma tissue, human brain tissue, human liver cancer tissue. Observed molecular weight by Western-blot: 45 kDa
-
Tested applications
ELISA, IF, WB, IHC
-
Species reactivity
Human, Mouse; other species not tested.
-
Alternative names
hNedd5 antibody; NEDD 5 antibody; NEDD5 antibody; SEPT2 antibody; SEPT2/septin 2 antibody; septin 2 antibody; septin2 antibody
-
Isotype
Mouse IgG1
-
Preparation
This antibody was obtained by immunization of SEPT2 recombinant protein (Accession Number: NM_001008492). Purification method: Caprylic acid/ammonium sulfate precipitation.
-
Clonality
Monoclonal
-
Formulation
PBS with 0.1% sodium azide and 50% glycerol pH 7.3.
-
Storage instructions
Store at -20℃. DO NOT ALIQUOT
-
Applications
Recommended Dilution:
WB: 1:20000-1:100000
IHC: 1:20-1:200
IF: 1:20-1:200
-
Validations

IF result of anti-SEPT2(Catalog No:107524, 1:1000) with hTERT-RPE cell by Dr. Moshe Kim. Green: SEPT2. Blue: DNA. 1% PFA fixed.

HEK-293 cells were subjected to SDS PAGE followed by western blot with Catalog No:107524 (SEPT2 Antibody) at various dilutions.
Immunohistochemistry of paraffin-embedded human renal cell carcinoma tissue slide using Catalog No:107524(SEPT2 Antibody) at dilution of 1:800 (under 10x lens). heat mediated antigen retrieved with Tris-EDTA buffer(pH9).

Immunohistochemistry of paraffin-embedded human renal cell carcinoma tissue slide using Catalog No:107524(SEPT2 Antibody) at dilution of 1:800 (under 40x lens). heat mediated antigen retrieved with Tris-EDTA buffer(pH9).
-
Background
SEPT2, also named as DIFF6, KIAA0158, NEDD5, belongs to the septin family. It is a filament-forming cytoskeletal GTPase. SEPT2 is required for normal organization of the actin cytoskeleton. It plays a role in ciliogenesis and collective cell movements. SEPT2 is coordinated expression with SEPT6 and SEPT7. (PMID:21737677)
-
References
- Garcia-Gonzalo FR, Corbit KC, Sirerol-Piquer MS. A transition zone complex regulates mammalian ciliogenesis and ciliary membrane composition. Nature genetics. 43(8):776-84. 2011.
- Calvo F, Ranftl R, Hooper S. Cdc42EP3/BORG2 and Septin Network Enables Mechano-transduction and the Emergence of Cancer-Associated Fibroblasts. Cell reports. 13(12):2699-714. 2015.
Related Products / Services
Please note: All products are "FOR RESEARCH USE ONLY AND ARE NOT INTENDED FOR DIAGNOSTIC OR THERAPEUTIC USE"
